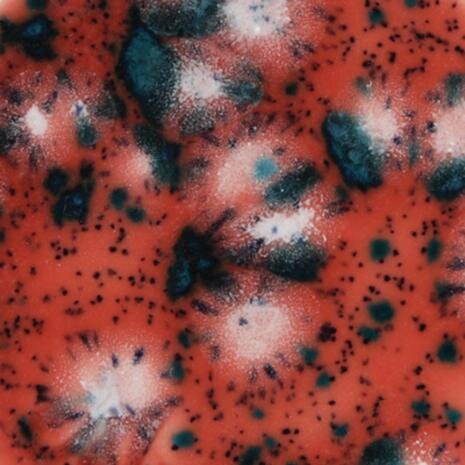

Mayco glaze - Jungle Gems Coral Puff
Regular price
Unit price
per
Tax included.
Specialist crystal glaze by Mayco118ml tubGlass effect glazes with small pieces of glass frit that melt during the firing process. This creates a randomised colour...
Specialist crystal glaze by Mayco
118ml tub
Glass effect glazes with small pieces of glass frit that melt during the firing process. This creates a randomised colour burst effect.
Fires to 999 - 1060°c